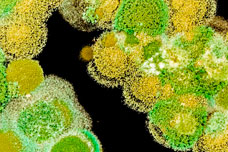

Интересные статьи



- 9 июня 2021
Сегодня легко потеряться, решая, какой тип сорт марихуаны выращивать. Бесчисленное количество штаммов, доступных на рынке,...


- 8 июня 2021
Всеобщий тренд использования исключительно органических продуктов вполне реализован и в культивировании конопли. Популярность...


- 7 июня 2021
Быстрое распространение культивирования каннабиса во всем мире привело к появлению новых природных ресурсов, которые приносят огромную...


- 24 апреля 2021
- 1 комментарий


- 24 апреля 2021


- 7 марта 2021
- 1 комментарий


- 7 марта 2021
- 1 комментарий


- 23 декабря 2020


- 3 ноября 2020
- 2 комментария


- 20 октября 2020
- 6 комментариев


- 30 сентября 2020


- 10 августа 2020


- 15 июля 2020


- 19 июня 2020


- 19 мая 2020



- 28 апреля 2020


- 28 апреля 2020



- 8 апреля 2020